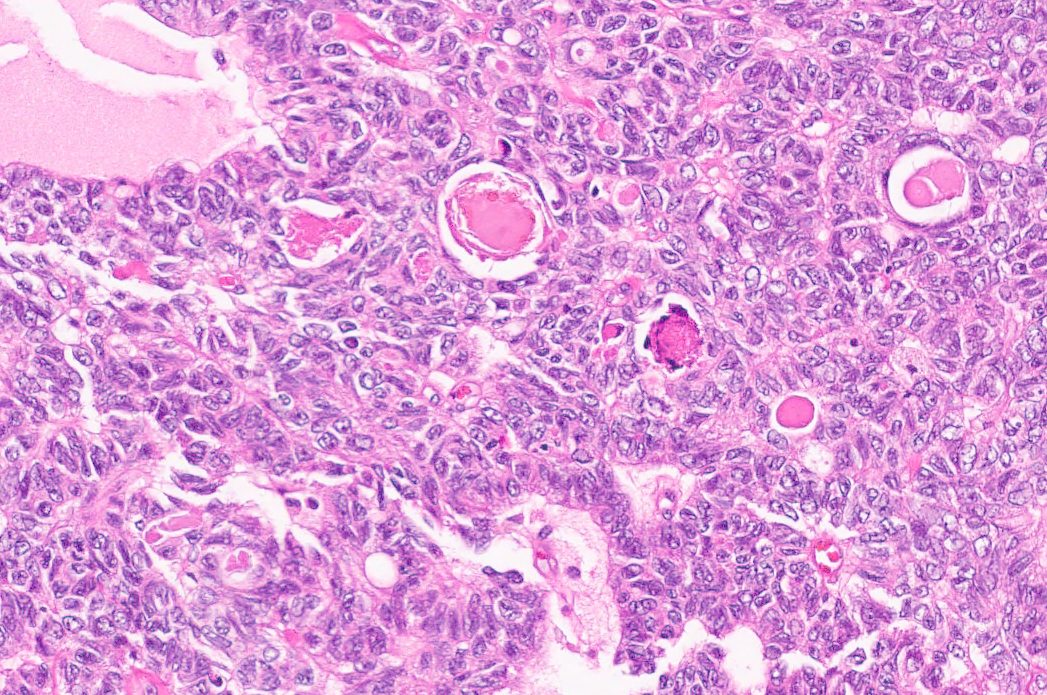
Gyn Mesonephric-Like Adenocarcinoma

Gynecologic Oncology & Reproductive Medicine
Pamela T. Soliman, M.D., M.P.H.
Department Chair ad interim
- Departments, Labs and Institutes
- Departments and Divisions
- Gynecologic Oncology and Reproductive Medicine
The Gynecologic Oncology and Reproductive Medicine department provides world-class comprehensive care of women with gynecologic cancers. As international leaders in the field, our physicians are driving innovations in cancer care through clinical trials, translational research, advanced surgical techniques and cancer prevention efforts.
Our faculty members treat patients with all types of gynecologic cancers, including:
- Ovarian cancer
- Endometrial (uterine) cancer
- Cervical cancer
- Vulvar cancer
- Vaginal cancer
- Gestational trophoblastic disease
In addition, we have specialty clinics focusing on cervix pre-invasive disease, high-risk ovarian cancer screening, oncofertility and acute gynecology issues in cancer patients.
Our physicians see patients at MD Anderson in the Texas Medical Center, at Lyndon B. Johnson Hospital, and at MD Anderson Houston-area locations in West Houston, Sugar Land, The Woodlands, League City, and at The Woman's Hospital of Texas.
We are dedicated to cultivating outstanding academic gynecologic oncologists, both clinician investigators and physician-scientists. Our four-year fellowship in Gynecologic Oncology is the largest such program in the United States. Three physicians are chosen each year to complete the clinical and research training, with a total of 170 program graduates since its inception in the 1950s.
FDA announcement on robotic surgery - departmental statement
In a February 2019 announcement, the Food and Drug Administration (FDA) issued a statement cautioning patients and providers about the use of robotic-assisted surgical devices for cancer-related surgeries. In the Gynecologic Oncology and Reproductive Medicine department at MD Anderson, minimally invasive radical hysterectomy (laparoscopy or robotic-assisted) is no longer performed in patients with early cervical cancer. In the setting of uterine cancer, there is evidence from prospective trials that the use of laparoscopy is safe and does not compromise oncologic outcomes, and thus we continue to offer a minimally invasive approach for appropriate patients. For additional information about minimally invasive radical hysterectomy vs. abdominal hysterectomy, read this story in Cancerwise.
Two-year research program for post-medical school graduates
The Gynecologic Oncology and Reproductive Medicine department will accept applications from those who have completed a foreign medical degree.
This position is designed to equip post-college and post-medical school graduates with clinical research skills. Candidates will acquire an advanced body of knowledge in protocol development, data acquisition and analysis, and presentation skills. Opportunities to observe in the clinic, operating room, tumor board, and other conferences will be incorporated.
This position has been funded by the McGregor Manne endowment and the Sie Foundation.

Dr. Tyler Hillman speaking with a patient in the Gynecologic Oncology clinic
Gyn Mesonephric-Like Adenocarcinoma

Dr. Pamela Soliman speaking with a staff member in clinic
Train With Us
Learn more about our distinguished four-year fellowship program and one-month elective rotation.
Care Center
Give Now
Research Areas
Find out about the four types of research taking place at UT MD Anderson.
